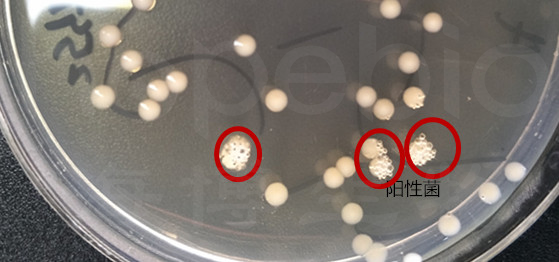

海博微信公众号
海博微信公众号
 海博天猫旗舰店
海博天猫旗舰店


 海博微信公众号
海博微信公众号
 海博天猫旗舰店
海博天猫旗舰店




一、培养基和试剂
培养基:普通琼脂斜面或巧克力琼脂平板培养基试剂:3%过氧化氢水溶液
二、试验原理
本试验是通过检查某些细菌是否产生过氧化氢酶以作为生化鉴定指标之一。过氧化氢酶可将过氧化氢分解成水并释放出分子氧,试验中可产生大量气泡。
三、试验方法 将待试培养物移种于上述培养基,于36±1℃培养18-24h。
(1)平板法:挑取单个菌落,置于洁净的载玻片上或小试管中,然后加入3%过氧化氢1-2滴,观察有无气泡产生。如有气泡产生,判断为阳性(如图1)。亦可在单个菌落上滴加1滴3%的过氧化氢,观察有无气泡(如图2)。

图1 载玻片上试验结果
图2 平皿菌落上试验结果
(2)斜面法:于培养18-24h琼脂斜面培养物表面加1ml3%过氧化氢,立即观察有无气泡产生。
四、注意事项
(1)本试验使用过氧化氢的浓度食品检验GB统一要求为3%。
(2)本试验不宜使用血琼脂的培养物,因红血球含有过氧化氢酶,可能造成假阳性结果,所以只采用已将红血球破坏的巧克力琼脂培养基。
(3)必须使用新鲜培养物,不得应用超过72h的培养物。因为只有活的细菌才会有过氧化氢酶,老培养物可能引起假阴性或弱阳性。
(4)挑取待试培养物,应使用白金针或环,不得使用含铁金属制成的接种针或接种环,因为微量的铁的污染,也可造成假阳性结果。
五、有关过氧化氢爆炸的一些说明
由于过氧化氢本身的不稳定性,遇有机物、金属、受热或见光都会分解生成氧气。所以必须避光、低温或常温保存。
在使用过氧化氢试剂时,可能会有部分过氧化氢分解产生的氧气积聚在试剂瓶的狭小空间内,导致瓶内气压较高。在掰开瓶口时,有时会听到“扑”地一声,偶尔会有类似爆炸的声音,甚至将瓶体炸裂或炸碎。所以,在掰开瓶口时,尤其要注意安全:
(1)严格参考产品的保质期,在保质期内使用;
(2)穿好实验服,带实验手套,做好常规防护;
(3)尽量在超净台等有防护罩的空间内掰开试剂瓶,或者眼睛尽量远离瓶口;
(4)为了更为保险,可以将试剂瓶置于小塑料袋中,在塑料袋的保护下掰开瓶口,以免爆裂的玻璃瓶碎片四处洒落。

注:本文属海博生物原创,未经允许不得转载。
上一篇:马尿酸钠水解试验现象及注意事项



